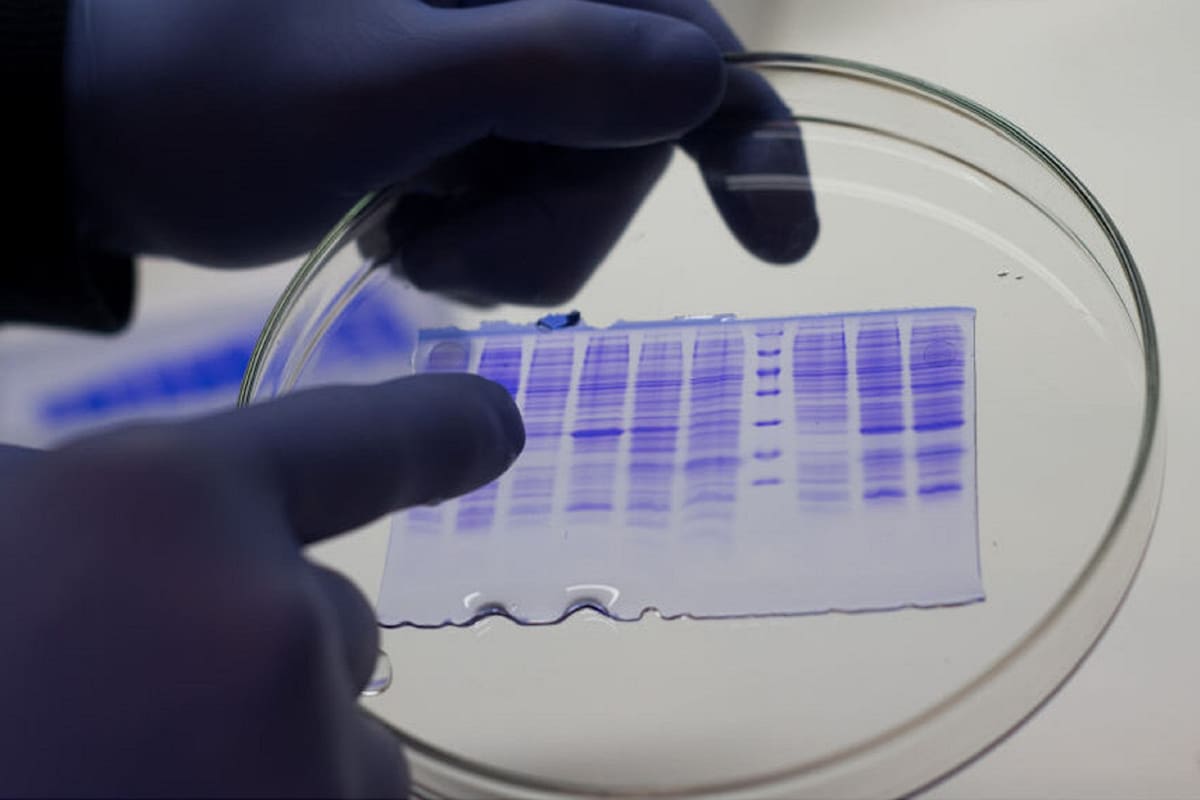
Las proteínas pasarían ahora a ensayos de laboratorio donde se comprobará su efecto antiviral

1 minuto de lectura'
1 minuto de lectura'
"Nos sentimos entusiasmados por estar intentando contribuir a combatir un problema tan serio, pero también sentimos la responsabilidad de ser muy cautos y meticulosos en cada uno de los pasos que damos". Así lo cuenta Enrique Detarsio, biotecnólogo líder del equipo del laboratorio Nova, que logró desarrollar dos proteínas que podrían, eventualmente, convertirse en una cura para el Covid-19.
El proyecto comenzó casi por casualidad. Hace dos meses, científicos extranjeros descubrieron que dos proteínas de cadena corta podían tener potencial antiviral contra el SARS-CoV-2. Detarsio, que es gerente de Investigación en Desarrollo en el Departamento de Enzimas de Nova, notó que tenían la capacidad de producirlas en su laboratorio y se decidió incursionar en esa línea. Para el agro ese laboratorio trabaja con inoculantes, herbicidas, bioestimulantes, insecticidas, entre otros productos.
El equipo logró producir las proteínas en pequeña escala. Pero había otro desafío. "Este tipo de proteínas son muy inestables especialmente en su comportamiento dentro del cuerpo", señala Mauro Piva, ingeniero agrónomo y presidente de Laboratorios Nova. "Se tuvo que realizar una modificación genética estructural para que duren la mayor cantidad de tiempo posible dentro del organismo", dijo. Para esto ayudó mucho la expertise del equipo, que desde hace ocho años se dedica a la producción de enzimas para diversas industrias (alimentaria, textil, farmacéutica y de biocombustibles).
Según explicó Detarsio a LA NACION, las proteínas impedirían que el virus infecte células humanas y limitaría de este modo que progrese la infección. Pero como aclara el biotecnólogo, aún no se ha comprobado su efectividad antiviral ni su seguridad ni eficacia clínica en seres vivos. "Se ha logrado dar un primer paso en un proceso de investigación y desarrollo que será extenso", dijo Detarsio.
Con el problema de la estabilidad resuelto, lo que viene ahora es la comprobación del efecto antiviral de estas proteínas. Según indica Piva, Nova ya está en contacto con el Instituto Malbrán, que se haría cargo de esa parte. "Son ensayos in vitro que se realizarán en laboratorios especializados en virología autorizados para este tipo de trabajos", comenta Detarsio, y enfatiza que, en esta etapa del desarrollo, "no se realizarán ensayos clínicos en seres humanos".
El presidente de Nova destaca el aliento que recibieron desde el comienzo de este proyecto de parte de la Secretaría de Ciencia, Tecnología e Innovación de la provincia de Santa Fe, donde está radicada la empresa. "Hoy nos siguen apoyando", comenta.
Además destaca la labor del Departamento de Enzimas. "Es un equipo joven, entusiasta, con bastante experiencia en producir y modificar proteínas", dice Piva acerca de los ocho científicos (siete biotecnólogos y un ingeniero químico) que integran ese Departamento. El equipo está conformado por Hipólito Chevalier, Celina Galles, Damián Demartino, Ezequiel Gullermo, Natalia Imelio, Diego Peralta y David Staropoli, y está coordinado por Detarsio.
 1
1La campaña de trigo invita a salir de la defensiva y jugar un partido al ataque
 2
2“La gran cosecha argentina”: el agro cerrará el primer cuatrimestre con un récord de 40 millones de toneladas exportadas
 3
3Estudio: calculan que si se eliminan las retenciones el Estado recupera el nivel de recaudación en cuatro años
 4
4“Es una locura”: advierten que un municipio bonaerense impuso un “tasazo” y hasta cobra por el alumbrado donde no hay luminarias





